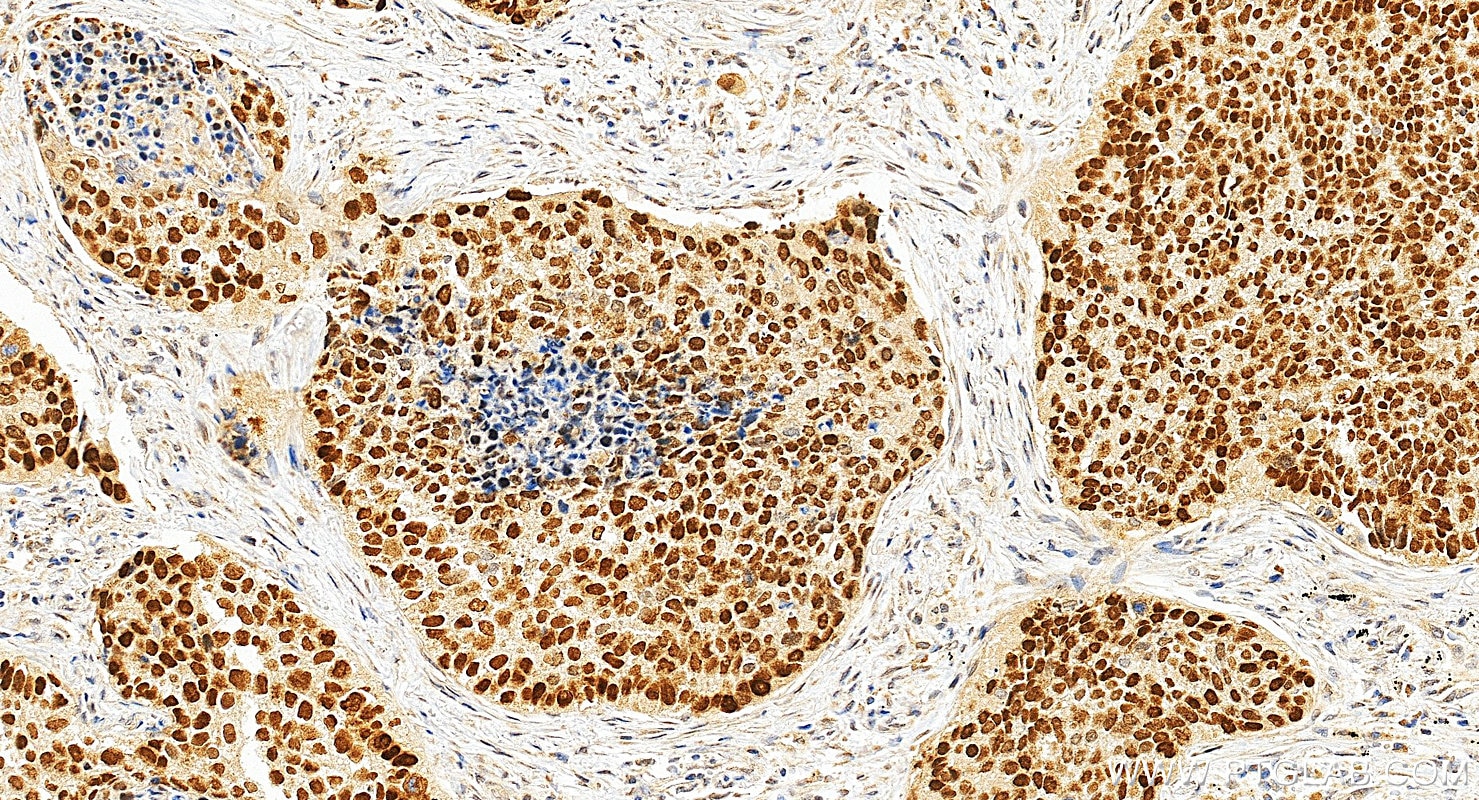
Immunohistochemical analysis of paraffin-embedded human lung cancer tissue slide using 12143-1-AP (p63 antibody) at dilution of 1:4000 (under 20x lens). Heat mediated antigen retrieval with Tris-EDTA buffer (pH 9.0). Immunohistochemistry (IHC) staining of human lung cancer tissue using p63 Polyclonal antibody (12143-1-AP)

Tested Applications
| Positive WB detected in | A431 cells, human heart tissue, mouse heart tissue, U-937 cells, Apoptosised HeLa cells, HaCaT cells, PC-12 cells, mouse thymus tissue |
| Positive IP detected in | A431 cells |
| Positive IHC detected in | human lung cancer tissue, human bowen disease tissue, human prostate cancer tissue, human tonsillitis tissue Note: suggested antigen retrieval with TE buffer pH 9.0; (*) Alternatively, antigen retrieval may be performed with citrate buffer pH 6.0 |
| Positive IF-P detected in | human lung cancer tissue |
| Positive IF/ICC detected in | A431 cells |
| Positive FC (Intra) detected in | A431 cells |
Recommended dilution
| Application | Dilution |
|---|---|
| Western Blot (WB) | WB : 1:500-1:3000 |
| Immunoprecipitation (IP) | IP : 0.5-4.0 ug for 1.0-3.0 mg of total protein lysate |
| Immunohistochemistry (IHC) | IHC : 1:2000-1:8000 |
| Immunofluorescence (IF)-P | IF-P : 1:50-1:500 |
| Immunofluorescence (IF)/ICC | IF/ICC : 1:500-1:2000 |
| Flow Cytometry (FC) (INTRA) | FC (INTRA) : 0.40 ug per 10^6 cells in a 100 µl suspension |
| It is recommended that this reagent should be titrated in each testing system to obtain optimal results. | |
| Sample-dependent, Check data in validation data gallery. | |
Published Applications
| KD/KO | See 3 publications below |
| WB | See 15 publications below |
| IHC | See 14 publications below |
| IF | See 19 publications below |
| IP | See 2 publications below |
| CoIP | See 1 publications below |
| ChIP | See 1 publications below |
Product Information
12143-1-AP targets p63 in WB, IHC, IF/ICC, IF-P, FC (Intra), IP, CoIP, ChIP, ELISA applications and shows reactivity with human, mouse, rat samples.
| Tested Reactivity | human, mouse, rat |
| Cited Reactivity | human, mouse, rat |
| Host / Isotype | Rabbit / IgG |
| Class | Polyclonal |
| Type | Antibody |
| Immunogen |
CatNo: Ag2791 Product name: Recombinant human TP63 protein Source: e coli.-derived, PGEX-4T Tag: GST Domain: 381-680 aa of BC039815 Sequence: NTHGIQMTSIKKRRSPDDELLYLPVRGRETYEMLLKIKESLELMQYLPQHTIETYRQQQQQQHQHLLQKQTSIQSPSSYGNSSPPLNKMNSMNKLPSVSQLINPQQRNALTPTTIPDGMGANIPMMGTHMPMAGDMNGLSPTQALPPPLSMPSTSHCTPPPPYPTDCSIVSFLARLGCSSCLDYFTTQGLTTIYQIEHYSMDDLASLKIPEQFRHAIWKGILDHRQLHEFSSPSHLLRTPSSASTVSVGSSETRGERVIDAVRFTLRQTISFPPRDEWNDFNFDMDARRNKQQRIKEEGE Predict reactive species |
| Full Name | tumor protein p63 |
| Calculated Molecular Weight | 680 aa, 77 kDa |
| Observed Molecular Weight | 63-68 kDa |
| GenBank Accession Number | BC039815 |
| Gene Symbol | TP63 |
| Gene ID (NCBI) | 8626 |
| RRID | AB_10597397 |
| Conjugate | Unconjugated |
| Form | Liquid |
| Purification Method | Antigen affinity purification |
| UNIPROT ID | Q9H3D4 |
| Storage Buffer | PBS with 0.02% sodium azide and 50% glycerol, pH 7.3. |
| Storage Conditions | Store at -20°C. Stable for one year after shipment. Aliquoting is unnecessary for -20oC storage. 20ul sizes contain 0.1% BSA. |
Background Information
TP63, also named KET, P63, P73H, P73L and TP73L, belongs to the p53 family. It is a homologue of the tumor suppressor p53 and p73 genes. It is involved in malignancy acquisition and maintenance of cells. Unlike p53, the p63 gene encodes multiple isotypes with remarkably divergent abilities to transactivate p53 reporter genes and induce apoptosis. TP63 acts as a sequence specific DNA binding transcriptional activator or repressor. TP63 has 12 isoforms with MW 40kd(P40), 50kd(P60),63kd(P63) and 73kd(P73L).
Protocols
| Product Specific Protocols | |
|---|---|
| FC protocol for p63 antibody 12143-1-AP | Download protocol |
| IF protocol for p63 antibody 12143-1-AP | Download protocol |
| IHC protocol for p63 antibody 12143-1-AP | Download protocol |
| IP protocol for p63 antibody 12143-1-AP | Download protocol |
| WB protocol for p63 antibody 12143-1-AP | Download protocol |
| Standard Protocols | |
|---|---|
| Click here to view our Standard Protocols |
Publications
| Species | Application | Title |
|---|---|---|
Nucleic Acids Res Activation of bivalent factor DLX5 cooperates with master regulator TP63 to promote squamous cell carcinoma.
| ||
Cell Rep A Wnt-induced lncRNA-DGCR5 splicing switch drives tumor-promoting inflammation in esophageal squamous cell carcinoma | ||
Oncogene TP53, CDKN2A/P16, and NFE2L2/NRF2 regulate the incidence of pure- and combined-small cell lung cancer in mice. | ||
Elife Chloride channels regulate differentiation and barrier functions of the mammalian airway. | ||
Stem Cell Res Ther Mesenchymal stromal cells promote the formation of lung cancer organoids via Kindlin-2 |
Reviews
The reviews below have been submitted by verified Proteintech customers who received an incentive for providing their feedback.
FH Tanusree (Verified Customer) (12-18-2019) | Product worked well in WB at 1:500 dilution
|
FH Kui (Verified Customer) (09-19-2019) | Best P63 Ab I can find so far.
![]() |